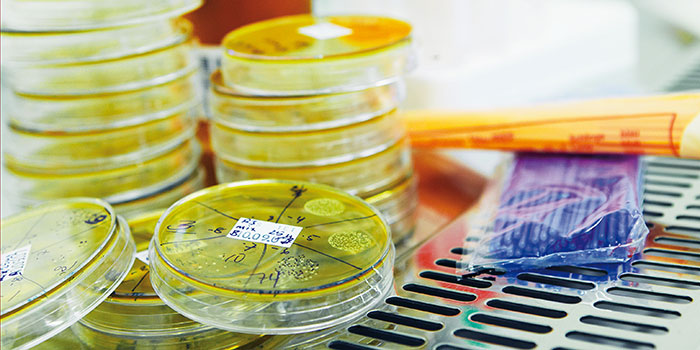

The following are merely examples of some of DTU's research in life science.
Microorganisms treat drinking water
Bacteria ensure that we can use our groundwater as drinking water. Unwanted substances such as ammonia, iron, and pesticides must be removed from our groundwater before we can use it as drinking water.
The groundwater can be treated using sand filters, which are several layers of different kinds of sand grains. At DTU Environment, research is conducted into how complex bacterial colonies contribute to sand filter water treatment. The researchers are also studying the various processes which occur inside the sand layers, as well as how to optimize sand filter efficiency.
Hans-Jørgen Albrechtsen, professor, DTU Environment,

Sensors save surgical patients
Small sensors can prevent life-threatening complications in newly-operated cancer patients. A third of patients who have undergone cancer surgery in the abdominal cavity will develop life-threatening complications. Body sensors can ensure 24/7 monitoring of newly-operated patients, so that complications are discovered earlier.
Researchers at DTU Electrical Engineering collect and analyse data from newly-operated patients to identify the signals which the body sends prior to occurrence of complications. Based on these data, the researchers develop computer algorithms which make it possible to alert healthcare personnel automatically in case of signs of changes in the patient’s condition. DTU collaborates with Rigshospitalet (Copenhagen University Hospital) and Bispebjerg Hospital on the project, which is funded by the Danish Cancer Society.
Helge Bjarup Dissing Sørensen, associate professor MSK, DTU Electrical Engineering,
Danish reference genome now mapped
By means of DTU’s supercomputer, researchers have acquired extensive knowledge about the shared genetic material of the Danes.
Using DTU’s supercomputer—Computerome (please see below)—researchers at DTU Bioinformatics have helped Danish researchers analyse 50 families’ genes. This has resulted in unprecedented precise knowledge of the Danes’ shared genetic material, known as the Danish Reference Genome. It can be used to acquire a better understanding of hereditary diseases and promote the development of personalized medicine.
Ramneek Gupta, associate professor, DTU Bioinformatics.
Global monitoring of antimicrobial resistance
Worldwide wastewater analyses map the incidence of global antimicrobial resistance. DTU Food analyses sewage from all over the world for antimicrobial-resistant bacteria and pathogenic microorganisms. The analyses are performed using so-called whole genome sequencing in which the complete DNA profile of the microorganisms is determined.
The data form part of global monitoring of resistant bacteria and diseases. This will contribute to knowledge about the mechanisms which cause diseases globally as well as how the bacteria are transferred between humans.
Frank Møller Aarestrup, professor, DTU Food.
Molecular understanding of Alzheimer's disease
Chemistry researchers are studying the role that the proteins which form brain plaque in Alzheimer’s patients play in the disease.
It is well known that Alzheimer’s patients have plaque deposits in the brain. But the presence of the plaque is not the triggering factor for the disease. The plaque consists of a number of amino acids, also called peptides, and researchers at DTU Chemistry have discovered—among other findings—that the more chaotic the structure of the peptides, the greater the risk of developing Alzheimer’s. The group is also looking at the complex of proteins behind the plaque production. The proteins are being studied at atomic level to understand how almost 200 protein mutations can cause Alzheimer’s disease. The vision is to discover pharmaceuticals which can cure or slow down the disease.
Kasper Planeta Kepp, professor, DTU Chemistry.

Laser for skin cancer diagnosis
Highly advanced laser sources are developed for devices which can be used in diagnosing skin cancer. Advanced and fast laser sources—the so-called supercontinuum sources—are known to emit a strong and highly broad-banded visible and near-infrared light.
Researchers from DTU Fotonik are developing new supercontinuum sources which instead emit mid-infrared light in what is known as the molecular fingerprint band. These laser sources can be included in imaging devices which can be used for fast, contactless examination of skin cancer. The technology can thus replace tissue biopsy.
Ole Bang, professor, DTU Fotonik.
Breast milk carbohydrates are produced in the laboratory
Researchers can produce the potent carbohydrates found naturally in breast milk. Breast milk contains large quantities of specialized carbohydrates unique to humans. Their properties are thought to play an important role in the development of infants’ immune system through—among other factors—the establishment of healthy intestinal flora in the infant.
At DTU Chemical Engineering, a research group has succeeded in producing some of these carbohydrates using enzymes and natural substrates. The vision is to utilize the carbohydrates—for example in food production—so that people will benefit from their health-promoting properties through functional foods.
Anne S. Meyer, professor, DTU Chemical Engineering.

Genetic analysis of fish
Fish DNA holds many answers about fish stocks in both oceans and fresh waters. Analyses of fish genes can, for example, determine whether the stocks adapt genetically, change their distribution, or shrink significantly during global warming.
Population genetics—as this field of research is called—is also a fish management tool used, for example, to assess whether releases can help an endangered stock. The analyses are also used to determine which fish species are caught and from which stocks they originate, so that overexploitation of small and vulnerable stocks is avoided.
Einar Eg Nielsen, professor, DTU Aqua.
Yeast cells produce haemoglobin
Genetically modified yeast cells can produce haemoglobin—the oxygen-carrying protein of the blood.
Researchers at DTU Biosustain have succeeded in genetically modifying yeast cells and making them produce large amounts of haemoglobin. The oxygen-carrying proteins in our blood are important for the ability to produce, for example, blood substitutes, used in blood transfusions. This new method may potentially revolutionize the way in which blood is normally produced for transfusions.
Jens Nielsen, Scientific Director, DTU Biosustain.

Immune system T cells to fight cancer
More in-depth knowledge of T cells may result in cancer patients’ own immune system fighting the disease. Some types of white blood cells—the so-called T cells—have the potential to recognize and destroy cancer cells.
Even though the defence mechanisms of cancer cells deactivate T cells, it is possible—in combination with medicine which inhibits the defence system of cancer cells—to activate the T cells, so that they target and kill the cancer cells. However, the challenge is that there are around 100 million different T cells patrolling our body, and it is not known how the individual T cells recognize the cancer cells. Researchers are working to develop a new technology which makes it possible to examine T-cell function in greater depth. The new knowledge can be utilized for immunotherapy in which the cancer is fought by the patient’s own immune system. This knowledge is also expected to have potential in treatment of arthritis, diabetes, and sclerosis.
Sine Reker Hadrup, professor, DTU Vet.
Supercomputer built for life science research
Computerome is Denmark’s national supercomputer for life science research, and it is located at DTU Risø Campus. When the supercomputer Computerome was plugged in, in 2014, it went straight to the 121st place among the world’s 500 most powerful computers.
Denmark’s biggest computer to date has a capacity corresponding to approximately 8,024 PCs connected to each other. Computerome thus adds massive computing performance to Danish life science research. Supercomputing or high-performance computing (HPC) makes it possible for researchers to combine large and complex data volumes. By connecting many computers and programming them to perform calculations based on carefully planned algorithms, it becomes possible to answer, for example, the question of how certain diseases are linked to particular genes, or learn more about the emigration of our early African ancestors.
Computerome’s ‘muscles’ currently consist of 17,864 CPUs (Central Processing Units) with an ultrafast memory of more than 108 terabytes, distributed on 590 servers. Its storage capacity is 8 petabytes, corresponding to 8,388,608 gigabytes. In comparison, a standard PC can typically store between 250-500 gigabytes. Its computing performance has a maximum capacity of 410.8 teraflops (flops = floating point operations per second). Computerome is funded by DTU, University of Copenhagen, and Danish e-Infrastructure Cooperation (DeiC).
Peter Løngreen, Director, Computerome, National Life Science Supercomputing Center.

Faster treatment of life-threatening bacterial infections
New technology can detect bacterial infection in the blood in a few hours and ensure that patients are treated quickly. Sepsis—blood poisoning—is a life-threatening condition in which an infection spreads and attacks organs and tissues.
The faster patients receive treatment, the greater their chances of survival. If sepsis is caused by bacteria, and they are spread through the blood, this can be detected quickly using new technology which DTU Nanotech has participated in developing and implementing in the ‘SmartDiagnosis' device. This device performs an analysis of a blood sample from the patient and can determine in just a few hours which bacteria are causing the infection and whether they are resistant to certain antimicrobial agents. In comparison, the present diagnostic methods can take up to three days for such determination.
Anders Wolff, associate professor, DTU Nanotech.
Utilization of beneficial properties of bacteria
Bacteria have the potential to produce antibiotic substances, enzymes, and other substances which may have beneficial medical effects.
Analysis of the bacterial genetic code (genome) reveals that bacteria have the potential to form a large number of bioactive substances which can be used for medical purposes—e.g. antimicrobial agents. But only some of these substances are known; probably because the genes coding the substances are ‘deactivated’. Research is being conducted into whether the cultivation of bacteria under conditions similar to their natural environment can activate the genes so that we can benefit from the substances. The research has been funded by Independent Research Fund Denmark and by Villum Fonden and includes a study of the marine bacteria which were collected from the sea during the Galathea 3 expedition just over ten years ago.
Lone Gram, Professor, DTU Bioengineering.

Mapping of the brain's network
Data from brain scans have been used to map the healthy brain. Brain scans can show how the different areas of the brain are connected, and thus reveal important information about the communication patterns of the brain.
However, brain scans provide a huge amount of noisy data, but—by processing them using statistical models and large-scale calculations—increased knowledge is acquired about the healthy brain. This may lead to improved diagnosis and treatment of diseases affecting the cognitive functions of the brain, such as Parkinson’s disease and multiple sclerosis.
Morten Mørup, associate professor, DTU Compute.

Together with Statens Serum Institut, DTU is responsible for the DANMAP programme which monitors the use of antimicrobial agents and the occurrence of antibiotic-resistant bacteria in animals, food, and humans.
The picture is of a salmonella bacteria.
Photo: Joachim Rode